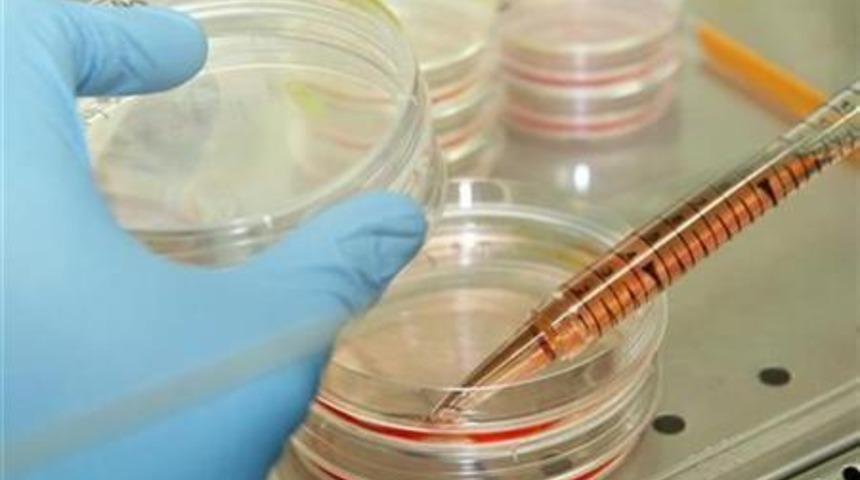
Dünyada bir ilk! Yeni doğan bebeğe karaciğer tedavisi için kök hücre!

Dünyada ilk kez gerçekleştirilen nakil sayesinde belli sorunlarla doğmuş olan bebekler için yeni bir tedavi yöntemi doğmuş oldu.
Nakil olan bebekte üre döngüsü hastalığı bulunuyordu. Bu hastalığa sahip insanların karaciğerleri toksik amonyağı ayrıştıramıyor.
6 günlük bebek tam karaciğer nakli ameliyatı için çok küçük olduğundan Ulusal Çocuk Sağılığı Merkezi'ndeki doktorlar 'köprü tedavi' adını verdikleri bir yöntem denemeyi kararlaştırdı.
Köprü uygulamalar hasta ameliyat olmak için gerekli metabolizmaya ve güce kavuşana kadar geçici olarak yapılan tedaviler için kullanılan bir ifade.
Böylece kök hücrelerden oluşturulan 190 milyon karaciğer hücresi bebeğin karaciğerine enjekte edildi.
Tedavi sonrası bebeğin kanındaki amonyak seviyesinin artmadığı görüldü ve tam karaciğer nakli için zaman kazanıldı.
Cinsiyeti açıklanmayan bebeğin geçirdiği işlemden 6 ay sonra babasının karaciğerinden bir parça nakil alarak taburcu edildiği öğrenildi.
Taburcu edildikten sonra da işlemin başarılı olması sebebiyle yapılan kök hücre işlemi hakkında basına bilgi verildi.
Ulusal Çocuk Sağlığı Merkezi Japonya'da kök hücre tedavisi denenmesine müsaade edilen ve yasalarda istisnası olan iki kurumdan biri.
Embriyolar ise doğurganlık ve üreme tedavisini başarı ile tamamlayan kadınlardan ve erkeklerden gönüllü bağışları ve onayları ile alınıp kullanılıyor.